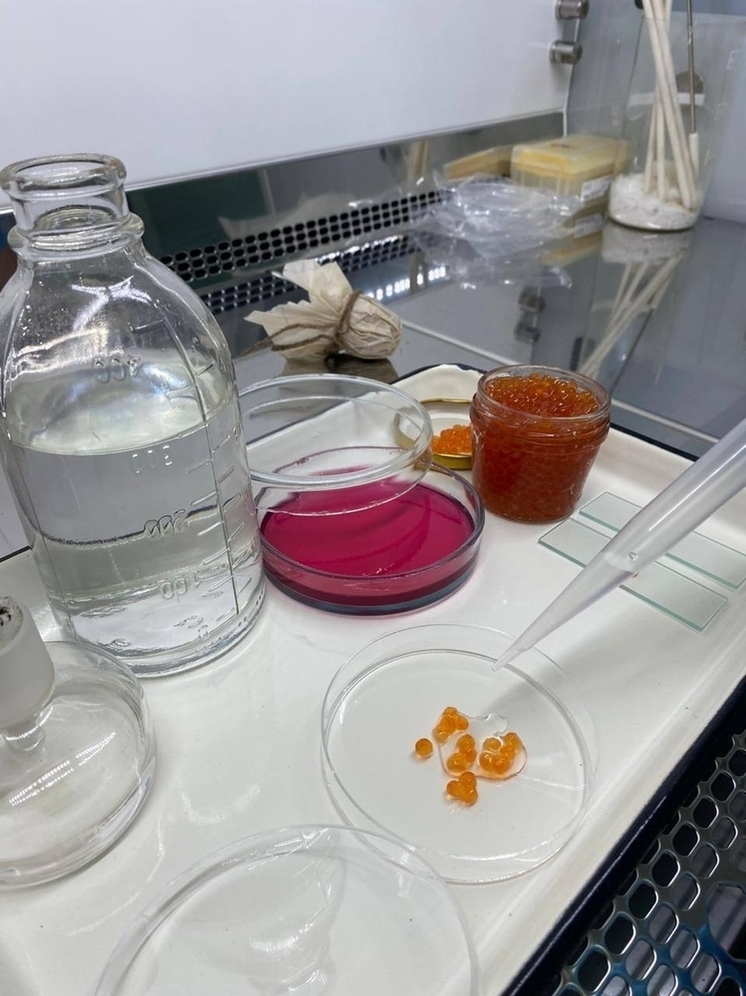
Качество красной икры проверено смоленскими специалистами

Специалистами Смоленской областной ветеринарной лаборатории проведено исследование качества красной икры перед Новым годом. Важнейшей задачей анализа было выявление фальсифицированной продукции и недопущение нарушения технологии производства.
Лаборатория установила, что в качественной икре недопустимо наличие патогенных микроорганизмов, включая кишечную палочку, стафилококки, сальмонеллу и анаэробы. К признакам неправильного хранения относятся избыточная жидкость, металлический вкус и запах, белый осадок, образование плесени и потемнение икринок.
Красная икра высшего сорта должна обладать определенными характеристиками: одинаковые по размеру зерна, чистый цвет, отсутствие посторонних примесей, влажная поверхность и легкое разделение икринок друг от друга. Исследования обеспечат безопасность потребителей и контроль над качеством продаваемого продукта.